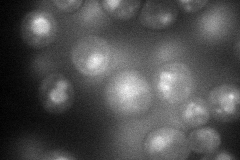
YCR028C
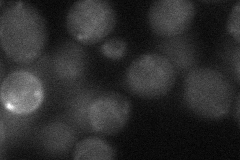
YCR028C
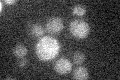
YCR028C

View description
Plasma membrane H+-pantothenate symporter; confers sensitivity to the antifungal agent fenpropimorph
Localization:
Intensity:
Fold change:
Significance:
-
C’ GFP library in SD

below threshold14.83 -
N' NOP1pr-GFP in SD
cell periphery,vacuole65.5413 -
N' TEF2pr-mCherry in SD

cell periphery,vacuole134.507 -
N' NATIVEpr-GFP in SD

missing0 -
N' TEF2pr-VC and Cyto-VN in SD
below threshold30.4543 -
C’ GFP library in SD+DTT

cytosol14.440.97No -
C’ GFP library in SD+H2O2

cytosol15.761.06No -
C’ GFP library in Starvation Media
cytosol16.171.09No -
C’ GFP library on the background of Pup2-DaMP

below threshold -
C’ GFP library on the background of CCT mutant

below threshold13.80470.930703No
